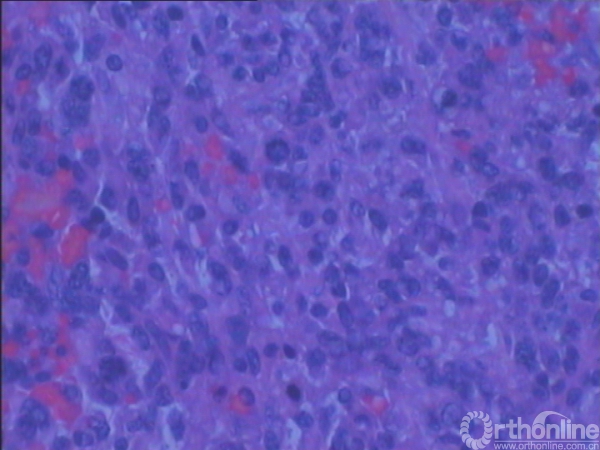

被误诊为“结节性筋膜炎”的恶性外周神经鞘瘤
2017-07-14 文章来源:北京积水潭医院骨肿瘤科 作者:王涛 牛晓辉 我要说
一、病例摘要
1.病史:女性,67岁,主因“发现右肘部包块24个月”收入院。患者24个月前无明显诱因出现右肘部后侧隐痛,且局部发现包块,与当地医院就诊,未明确诊断;17个月前疼痛加重,包块更加明显,于12个月前于当地医院行“肿物切除术”,术后病理示“结节性筋膜炎”;4个月前于原切口处再次出现包块,1个月前再于当地医院行“肿物切除术”,术后病理示“恶性外周神经鞘瘤”,为求进一步诊治收住入院。
2.体格检查:右肘关节后侧可见两处手术疤痕(图1),各长约6cm、4cm,偏尺侧可触及直径约2cm肿物,质硬,边界不清,无活动度,可及压痛,局部皮肤颜色及皮肤温度未见异常,右肘关节活动无受限,右前臂及手感觉、肌力未见异常,右桡、尺动脉搏动可触及,右腋窝及肘窝淋巴结未触及肿大。

图1:外观像(右肘关节后面观)
3.辅助检查:化验检查未见明显异常。B超显示右肘关节后方软组织内可见实性杂乱回声包块,1.5cm×1.0cm,界欠清,其内回声不均,可见少许血流信号。手术切口上端深处紧贴尺骨可见低回声小包块,0.9cm×0.2cm,未见血流信号。MRI(图2)示右肘关节后方皮下组织内可见软组织肿块影,边界不甚清楚,T1加权像呈现低信号,T2加权像呈中高信号,增强后T1加权像呈高信号,抑脂像亦呈现高信号。会诊病理(图3)显示成片较密集的轻度-中度间变的短梭形细胞,纤维性间质局部粘液变。初步考虑梭形细胞肉瘤Ⅱ级,可符合恶性外周神经鞘瘤形态。

图2a:T1加权像

图2b:增强后T1加权像

图2c:T2加权像

图2d:抑脂像
图3:病理组织学镜下像(×200,H-E染色)
4.诊断:右前臂近端软组织恶性外周神经鞘瘤
5.治疗:入院后行手术治疗。取距原手术切口3cm做皮肤切口,于肿块外正常软组织2cm,包含皮肤、皮下组织、肿块、深筋膜及其深层的肌肉整体切除,以同侧背阔肌肌瓣旋转后经腋下、上臂后侧皮下隧道覆盖软组织缺损,再以所取之背阔肌肌瓣之表层全厚皮片作游离植皮覆盖伤口。切下之肿物(图4 标本大体像)切面呈灰白色,质地中等。

图4a:内面观

图4b:外面观
二、病例分析与讨论
恶性外周神经鞘瘤多发生于20~50岁人群,有1/4至1/2伴发于神经纤维瘤病1型。常见部位为上肢、下肢的近端和躯干,大多数与大神经干相关,包括坐骨神经、臂丛、骶丛等。其临床特征与其他软组织肉瘤没有太大区别,通常表现为数月内增大的软组织肿块,伴或不伴有疼痛,而发生于大神经干的则常有放射性疼痛、麻木或肌力减退。病理学大体表现类似于其他软组织肉瘤,直径通常大于5cm,呈现鱼肉样、不透明、灰褐色的外观,伴发出血和坏死。镜下表现则大多与纤维肉瘤类似,细胞呈梭形或短梭形,细胞密集生长,其间穿插着粘液样区域,,从而呈现出大理石样的外观,细胞核轻度深染,可见病理核分裂像,透明带和小结节为其特征性表现。
结节性筋膜炎是一种良性纤维增生性疾病,多发生于20~40岁人群,多为单发,多见于皮下组织和深筋膜,少见于肌肉内,常见发生部位为上肢、躯干、头部和颈部。该病多生长迅速,病程多在1月内,表现为逐渐增大的局部肿块,但直径多小于2cm,少有大于5cm,可有局部酸胀不适或轻度疼痛,若有局部神经压迫则有麻木和放射性疼痛。病理学大体表现通常直径在2cm以下,没有包膜,可呈现侵袭性生长的特征,剖面结构表现各异,可有粘液、纤维性结构,甚至是囊性结构,可以类似于粘液瘤、腱鞘囊肿、神经鞘瘤、纤维瘤病,甚至是纤维肉瘤、恶性外周神经鞘瘤等。病理镜下表现包含大量不规则的短梭形纤维母细胞,大小和性状均一一致,可排列成束状,细胞核呈卵圆形,多为浅染,没有多形性,可见有丝分裂相,但少见非典型性,另外可有少量的胶原和粘液。该病预后良好,切除后复发率很低,一般小于2%,几乎不恶变,没有转移。主要的鉴别诊断包括纤维瘤病、纤维肉瘤、恶性外周神经鞘瘤、恶性纤维组织细胞瘤等。
纤维瘤病为良性侵袭性病变,常见于肢体近侧和躯干的肌肉内,病史可长达十数年,可缓慢增长至很大,多数无疼痛症状。病例特征为白色、致密、固定的肿块,一般无包膜,常与周围肌肉、肌腱、筋膜无明显分界,甚至穿插生长。镜下表现为无细胞结构的成熟胶原呈束状排列,可见少量成熟的纤维细胞,但少见有丝分裂相。
结节性筋膜炎常常由于其快速生长、细胞丰富、有有丝分裂相等特征而被误诊为软组织肉瘤,包括纤维肉瘤、恶性外周神经鞘瘤、恶性纤维组织细胞瘤等。临床上鉴别主要靠肿瘤的大小和部位,一般来说,直径超过5cm、位于深筋膜深层,肉瘤的诊断可能性较大。病理上主要取决于细胞的形态和细胞核的染色程度和异型性,一般说来肉瘤的细胞形态大小不一,细胞核大、深染、有丝分裂相常见、多见非典型性或病理性有丝分裂相。
对疑为软组织肉瘤的病变进行活检是治疗过程中重要的第一步。活检不仅能证实诊断、确认组织类型和确定分级/分期,而且所选用的活检技术和操作过程也会对治疗结果造成直接的影响。所有的活检通道(包括细针抽吸、针刺活检、套管针活检、切开活检和切除活检)在手术时都需要完整切除。活检应由行确定手术的医师亲自操作或在他的指导下进行。活检部位的选择应以手术时需要再切除的组织最少为原则。活检时应小心避免如下情况:横行切口、暴露主要的神经血管束、过量的出血以及肿瘤组织污染邻近组织。应特别注意止血(包括使用止血带),避免污染假包膜外的正常组织。基于同样原因,活检后避免使用引流。细针抽吸/细胞学检查或穿刺活检/冰冻切片技术污染正常组织的风险较小,因此首选这两项技术。当这两项技术所提供的材料不足以明确诊断时,再行切开活检。切除活检不可避免地增加了污染的风险,因此,只要有可能诊断为肉瘤的病例均应避免施行切除活检。在完成足够的影像学检查之前,不应盲目进行活检。因为组织对活检的反应往往影响后来的影像学检查结果。活检也不应作为决定是否转诊的依据。如果首选转诊,那么基于上述种种原因,转诊之前不应该施行活检。
外科手术仍是治疗软组织肉瘤的主要手段。多种因素影响手术治疗成功率,包括肿瘤的分期、解剖部位、解剖深度、肿瘤大小、浸润周围组织的情况、是否需要一期关闭伤口或者需要整形外科组织重建等。患者的一般情况,手术范围、方式及手术技巧亦是重要的影响因素。因此,在明确肿瘤组织学诊断基础上制定完善的术前计划至关重要。充分的切除边界是距肿瘤组织6厘米进行切除,尽量将整个间室切除。但从文献上看这种理想的切除边界难以达到。这种方式需要至少切除直径超过12cm的正常组织,在所有的上肢和膝关节以远的肉瘤只有进行截肢才能达到这个要求。然而在过去即使是二十世纪60年代也只有40-47%的病例采用了截肢手术。目前对肢体肉瘤病人更强调生活质量,多采用保肢手术同时应用其他多种辅助治疗措施。以外科手术治疗为主,同时使用动脉化疗、动脉化疗加放疗或放疗等。在肿瘤中心肢体肉瘤的目前的截肢率在5%左右。在肉瘤广泛累及关节或骨和软组织时可以采用截肢手术。如主要神经受累,像坐骨神经,则可将神经和肿瘤组织一起切除。一根主要神经受累不一定进行截肢手术治疗,切除一根神经带来的功能损失要比损失一个肢体好处理的多,病人也更容易适应。恰当的手术边界由病变的分期以及病变和病人对术前辅助放疗的反应决定。
低度恶性的I期病变,在无辅助放疗时需要广泛的外科边界,在术前放疗反应满意的情况下,可采用边缘性切除。满意的放疗反应是指形成放射线诱导的包膜壳,伴或不伴肿块体积的减小。放疗后复查MRI 以确定放疗反应是必要的。对于IA期病变,若可行广泛切除而不损失主要的骨和/或神经血管束,则仅用手术治疗即可。对于那些要广泛切除肿瘤就有可能损失主要的骨和/或神经血管束的患者,可以采用边缘性手术加放疗的方法进行治疗,这样可以明显地保留功能。IB期肿瘤需要同样的手术边界。如果术前放疗满意,可以使用边缘性切除以保留肢体。如果放疗反应不满意,并且广泛性切除是不可行的,则应行广泛性截肢。高度恶性IIA期病变需要行单独的根治性手术(通常可达到根治性边界并保留肢体)或者满意的放疗反应加广泛的手术切除。如果要达到广泛的外科边界必须行大动脉的移植,那么先行手术治疗,放疗在术后进行,因为术前放疗则有动脉突然爆裂/截肢的危险。如果对放疗的反应不满意,则可选择根治性间室外切除(损失主要的骨/神经血管束)或根治性截肢。权衡上述两种术式,选择能够获得较好功能的手术方法。IIB期肿瘤需要相同的边界:满意的放疗反应加广泛性切除或不满意的放疗反应加根治性手术。即使放疗反应满意,行边缘性手术局部复发率仍高得令人难以接受。相对于IIA期,IIB期肿瘤间室外结构复杂,要达到根治性边界往往需要截肢,特别那些在骨盆带或肩胛带附近的肿瘤更是如此。此外,截肢后应用设计制作良好的假肢往往可获得比勉强保留下的肢体更好的功能。
(王涛 北京积水潭医院骨肿瘤科 100035)
三、专家点评
恶性外周神经鞘瘤由于其临床和病理学的不典型性,很容易与其他软组织肉瘤相混淆;而结节性筋膜炎常常由于其快速生长、细胞丰富、有有丝分裂相等特征而在临床和病理学被误诊为软组织肉瘤。这例患者就是一例被误诊为结节性筋膜炎的恶性外周神经鞘瘤,这就时刻提醒我们对于非典型病例或诊断有疑难的病例,首先要完善影像学检查,作为诊断的依据、病理活检的指导以及手术切除的边界评价;其次要进行适宜的活检,穿刺活检以其污染少、准确率高而成为首选。手术则遵循广泛切除的原则进行,一切盲目的手术和不规范的手术都会给保肢手术造成困难。虽然现在恶性肿瘤保肢治疗已经成为主流,且各肿瘤中心关于保肢率的报告均很高,但对于那些放疗和化疗不敏感、或因肿瘤大小及解剖部位的原因而无法达到根治或广泛切除的外科边界的患者,下决心进行广泛切除边界以上的外科手术甚至是截肢,无论对医生还是患者,都是至关重要的。
(牛晓辉 北京积水潭医院骨肿瘤科 100035)
参考文献
1 Flether CDM,Unni KK,Merterns F. Pathology and Genetics of Tumours of Soft Tissue and Bone. IARCPress,Lyon,2002
2 Weiss SW,Goldblum JR. Enzinger and Weiss’s Soft Tissue Tumors Fourth edition. A Harcourt Health Sciences Company, 2001
3 Enneking WF. Musculoskeletal Tumor Surgery. Churchill Livingstone, 1983
4 Malawer M, Sugarbaker PH. Musculoskeletal Cancer Surgery: Treatment of Sarcomas and Allied Diseases. Kluwer Academic Pub November, 2000. 243-278
5 Kawaguchi N, Ahmed AR, Matsumoto S, et al. The concept of curative margin in surgery for bone and soft tissue sarcoma. Clin Orthop Relat Res. 2004 Feb;(419):165-72
6 Enneking WF, Spanier SS, Goodman MA. A system for the surgical staging of musculoskeletal sarcoma. 1980. Clin Orthop Relat Res. 2003 Oct;(415):4-18





 京公网安备11010502051256号
京公网安备11010502051256号